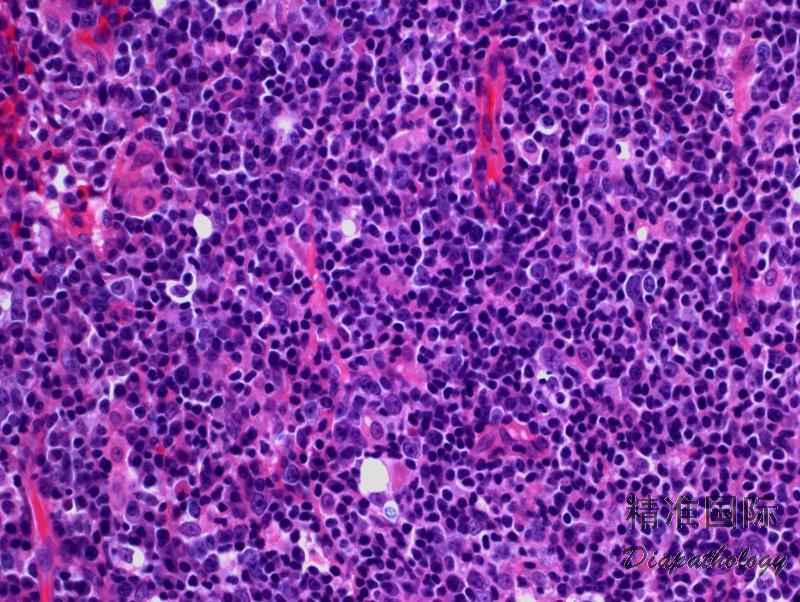

淋巴结边缘区淋巴瘤
Nodal Marginal Zone Lymphoma, NMZL
同义词(或曾用名): “单核细胞样”B 细胞淋巴瘤
概述:
结性边缘区淋巴瘤是原发自淋巴结内的 B 细胞淋巴瘤,形态上类似结外边缘区淋巴瘤累及淋巴结。因此,诊断前需除外结外淋巴瘤包括 MALT 淋巴瘤和 SMZL。
发病部位: 外周淋巴结,少数侵犯骨髓,外周血累及罕见。
诊断要点:
- 发病中位年龄 60 岁,女性稍多。表现为局部或广泛的外周淋巴结肿大,少数患者有 B 症状。
- 肿瘤细胞沿边缘区或滤泡间增生,导致边缘区或滤泡间扩张,可见残存滤泡;或更广泛弥漫浸润致淋巴结正常结构不复存在。
- 肿瘤细胞形态多样,呈单核样、中心细胞样和浆细胞样,并总是混有散在的转化细胞或淋巴母样/免疫母样细胞。时转化细胞数甚至超过 20%,但其中混有小淋巴细胞,且多见于植入的滤泡。
- 有时会发生广泛的瘤细胞滤泡内“植入”, 形态上易与滤泡淋巴瘤混淆。
- 免疫表型:表达 B 细胞抗原,近半数病例合表达 CD43, 强表达单克隆轻链。一般 Bcl-2 阳性,少数病例表达 CD5,一般不表达 CD10 和 Bcl-6。75%病例 MNDA+和 IRTA1+(滤泡淋巴瘤阴性)。
- 无特异细胞遗传异常,有报道+3,+7,+12
- Ig 基因克隆性重排。大多数病例检测到 Ig 可变区基因的体细胞超突变。
变异型:
儿童淋巴结边缘区淋巴瘤 :
男童多见(男女之比为 20:1),常无症状,表现为局限性头颈淋巴结肿大。组织形态学与成人 NMZL 类似,但常有显著滤泡增生扩大,套区细胞延入滤胞,类似进行性滤胞中心转化;滤胞间区扩大,肿瘤细胞浸润,滤泡边缘破坏。免疫表型也与成人的相同。主要需与不典型边缘区增生鉴别。不典型边缘区增生可出现 CD43 合表达和浆细胞限制性轻链表达,但无 IgH 重链基因克隆型重排。故所有儿童结边缘区淋巴瘤病例都应做 Ig 基因重排检测才能确诊。儿童 NMZL 行保守治疗,很少复发,预后极佳。

分子标记:
无特异细胞遗传异常。Ig 基因克隆性重排;大多数病例检测到 Ig 可变区基因的体细胞超突变
鉴别诊断:
- 结外边缘区淋巴瘤 (MALT 淋巴瘤) :MALT 淋巴瘤可累及淋巴结,形态上与结边缘区淋巴瘤类似,但临床有 MALT 淋巴瘤病史,常见反应性滤泡和完整套区,瘤细胞呈明显单核细胞样形态,IgD 几乎都阴性,且常有特征性的染色体易位如 t(11;18)(q21;q21)/API2-MALT1
- 淋巴浆细胞淋巴瘤 (LPL):两者在形态学和免疫学特点经常重叠。NMZL 的细胞组成常较为多形性,而组成 LPL 细胞相对为形态单一的小细胞和浆细胞,后者常含 Dutcher 小体,窦区结构常保留。血浆电泳检测到较明显的 IgM 峰值,有 MYD88 体细胞基因突变。
- 滤泡性淋巴瘤(FL) 伴边缘区分化:偶尔滤泡淋巴瘤会出现边缘区分化,呈边缘区分化的瘤细胞胞浆丰富或如单核样细胞,分布在肿瘤滤泡外围,套区减小或消失。呈边缘区分化的瘤细胞实为肿瘤滤泡的一部分,这部分细胞常弱表达 Bcl-6,CD10 也表达低下。当 NMZL 伴滤泡植入时,需与滤泡淋巴瘤鉴别,有时鉴别很困难,免疫组化(滤泡中心细胞标记 Bcl-6. CD10. HGAL、LMO2 和 NMZL 肿瘤细胞标记 MNDA、IRTA1)和遗传学(BCL2/IGH)应该有帮助。
- 慢性淋巴细胞白血病/小淋巴细胞淋巴瘤 (CLL/SLL):CLL/SLL 偶尔会沿滤泡间或滤泡旁分布,看上去类似 NMZL。 但 CLL 细胞为小圆形,有增值中心,合表达 CD20(弱),CD5 和 CD23,IgD 也阳性。
- 弥漫性大 B 细胞淋巴瘤 (DLBCL):当 NMZL 呈现弥漫生长并有大量转化细胞(中心母细胞样或免疫母细胞样)时,须与 DLBCL 或 DLBCL 转化鉴别。一般认为,只由大细胞呈实性片状时,才诊断为 DLBCL。
预后:
NMZL 属低级别的 B 细胞淋巴瘤。5 年生存率约 60%。少数病例转化成弥漫大 B 淋巴瘤,病情恶化。
